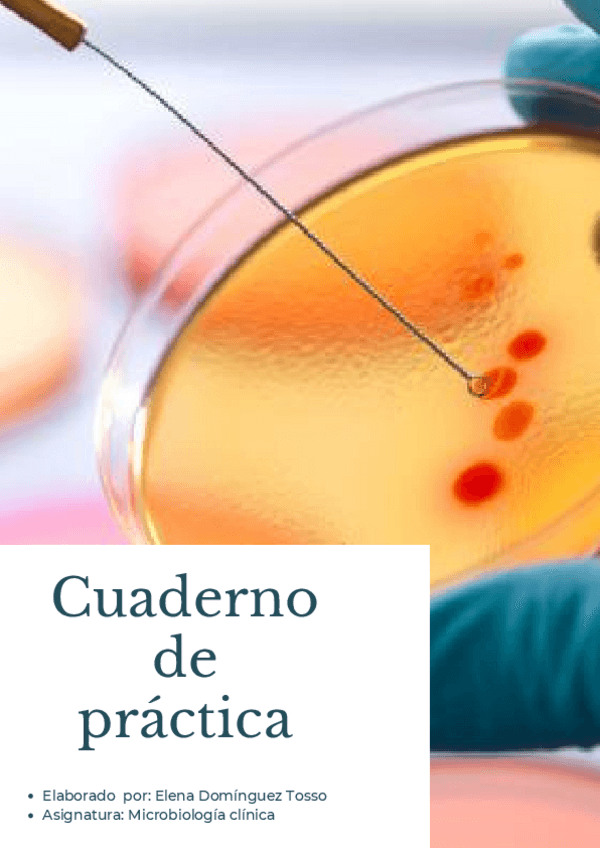

@Elena_Tosso0
21 Publicaciones
154 Interacciones
4 Seguidores
0 Siguiendo
Lista de publicaciones de Elena_Tosso0
He publicado nuevos apuntes de 1º Historia de la enfermería: Preguntas-examen-contestadas.pdf
He publicado nuevos ejercicios de 1º Bioestadística, Metodología de la Investigación y Tecnología de la Información y Comunicación en Cuidados de Salud: Cuadernillo-resuelto.pdf
He publicado nuevos apuntes de 1º Bases Teóricas y Metodológicas de los Cuidados de Enfermería: Preguntas-autoevaluacion.pdf
He publicado nuevos apuntes de 1º Bases Teóricas y Metodológicas de los Cuidados de Enfermería: TEMA-10.pdf
He publicado nuevos apuntes de 1º Medio Ambiente y Salud: TEMAS-COMPLETO-MEDIOAMBIENTE.pdf
He publicado nuevos apuntes de 1º Bases Teóricas y Metodológicas de los Cuidados de Enfermería: Temas-del-1-al-5.pdf
He publicado nuevos apuntes de 1º Bases Teóricas y Metodológicas de los Cuidados de Enfermería: Temas-del-5.2-al-9.pdf
apuntes
-
bioquímica
He publicado nuevos apuntes de Análisis bioquímico: bioquímica
apuntes
-
microbiología cuaderno de práctica y apuntes
He publicado nuevos apuntes de Microbiología Clínica: microbiología cuaderno de práctica y apuntes
apuntes
-
proyecto de empresa
He publicado nuevos apuntes de Empresa e Iniciativa Emprendedora: proyecto de empresa
apuntes
-
cuaderno de hematología-compressed_merged
He publicado nuevos apuntes de Técnicas de análisis hematológico: cuaderno de hematología-compressed_merged